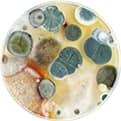

Залишити квартиру на 2-4 години в залежності від методу обробки.

Виїзд у будь-який зручний
для Вас час, навіть уночі

Гарантія на обробку
6-12 місяців

Європейські препарати,
сертифіковані


Знищення тарганів

Дезінфекція
у приміщенні

Дезінфекція
в транспорті

Дезінфекція
вентиляції

Дезінфекція
підприємств

Знищення
тарганів

Санітарна
обробка

Фумігація

Дезодорація
Ольга Сидоренко
менеджер
Позбавимо Вас всІх вІдомих комах, шкІдливих мІкроорганІзмІв

Виїзд у будь-яке зручне для Вас час, навіть уночі
По області в тому числі! Ціна вказана
вже із виїздом. Можемо приїхати терміново
у день замовлення і навіть уночі!

Співробітники одні з найкращих в Україні
Усі наші співробітники ідеально знають
свою справу. Проходять перевірку у службі
безпеки.

Тільки найкращі препарати
Європейські препарати,
сертифіковані. Не залишають
слідів і не псують ремонт!

Безпечно навіть для найменших дітей!
Підбираємо потрібні препарати для Вашої
проблеми та не перетравлюємо приміщення
понад звичайне.

Конфіденційно
Ми гарантуємо конфіденційність,
не розголошуємо хто і що замовляє у
нас. Це наш регламент!

Комахи - рознощики
інфекцій. Особливо це
небезпечно для дітей!
Грибок поширюється, спори
дуже токсичні, чим його більше - тим
токсичнішим він стає.
Якщо не позбавлятися проблем, рано чи пізно почнуться
проблеми зі здоров'ям.
Не доводьте до цього, бережіть своє здоров'я і своїх близьких!
викликати фахівцяЧи потрібно виходити з квартири і скільки триває процедура?
Залишити квартиру на 2-4 години в залежності від методу обробки.
А якщо не пропадуть комахи?
Ми даємо гарантію від 6 до 12 місяців. на роботу: якщо комахи не пропадуть, повторна робота майстра буде дешевшою
Як чинити з дітьми, квітами чи тваринами?
Препарати європейської якості і для людини шкоди не несуть, якщо будьте дотримуватися рекомендацій нашого фахівця. На квіти обробка ніяк не впливає, тварин можна повертати після обробки.
Чи допоможе обробка, якщо квартира захаращена?
Туман проникає у всі важкодоступні місця, тому так
Чим обробляємо, наскільки сильний запах та наскільки це шкідливо?
Є обробка із запахом є без запаху, запаху у хімії немає, якщо обробляти без запаху ретельне прибирання робити не треба, тільки протирати робочу поверхню
Що потрібно прибирати з ванної, кухні?
З кухні забираються всі негерметично упаковані продукти харчування.
У ванній кімнаті всі мочалки, зубні щітки, рушники та інші відкриті предмети особистої гігієни.

Люди та тварини

Дитячі іграшки та постільна білизна

Продукти харчування

Що після обробки
Вони проконсультують Вас з Вашої проблеми і дадуть відповіді на всі питання.
Залишайте заявку і менеджер зв'яжеться
з Вами протягом 5 хвилин (в робочий час)
Ольга Сидоренко
менеджер
Натискаючи на кнопку відправити, я приймаю умови передачі інформації

Ми зв'яжемося з Вами протягом 5 хвилин

з Вашої проблеми у нашого найкращого менеджера протягом 5 хвилин

Ми зв'яжемося з Вами протягом 5 хвилин

Замовляйте дезінсекцію тарганів із гарантією 6-12 міс.
У момент залишення заявки з клієнтом укладається договір, в рамках якого у разі появи шкідників після проведення очищення майстер проведе повторну дезінфекцію ДЕШЕВШЕ.

Протягом 5 хвилин